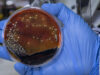

صراحة نيوز-أعلنت وزارة الخارجية الأردنية متابعة حالة وفاة ثلاثة أطفال من عائلة أردنية، إثر حادث سير وقع في المملكة العربية السعودية الشقيقة.
وأوضحت الوزارة أن الحادث وقع أثناء عودة العائلة إلى الأردن قادمة من دولة قطر الشقيقة، مؤكدة تقديم كل الدعم اللازم للأهل في هذه الظروف الصعبة.
وقالت وزارة الخارجية الأردنية، الأربعاء، ان مديرية العمليات والشؤون القنصلية في الوزارة تتابع حادثة وفاة ثلاثة أطفال من عائلة أردنية إثر حادث سير وقع في المملكة العربية السعودية ، أثناء طريق عودتهم إلى الأردن قادمين من دولة قطر.
وقال الناطق الرسمي باسم الوزارة السفير د. سفيان القضاة إن الوزارة من خلال مديرية العمليات والشؤون القنصلية، والسفارة الأردنية في الرياض، تابعت الحادث منذ وقوعه مع السلطات المعنية في المملكة العربية السعودية الشقيقة، مُبيّنًا أن الحادث أسفر عن وفاة الأطفال الثلاثة، وإصابة الأب والأم برضوض.
وأشار السفير القضاة إلى أن الوزارة ستقوم بإخلاء طبي للمصابين واتخاذ الاجراءات اللازمة لنقل جثامين الأطفال الثلاثة إلى المملكة بناء على رغبة ذويهم، مُعرِبًا عن أصدق التعازي والمواساة للعائلة الأردنية لوفاة أطفالهم، سائلًا المولى عزّ وجل أن يتغمّدهم برحمته ومغفرته، ويلهم ذويهم جميل الصبر وحسن العزاء، مُتمنيًا الشفاء العاجل للمصابين.